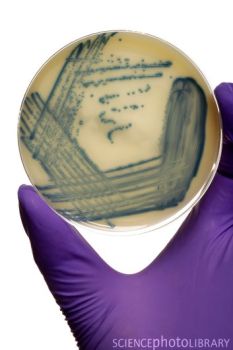

《科学家》杂志网站11月30日发表了一篇关于癌细胞的综述文章,列举了近年来科学家们发现癌细胞在抗癌药物攻击下的几条逃生路线,以帮助我们了解这些癌细胞的“不死之谜”。
自从人类发现癌细胞开始,人类和癌症的战争就从来没有停止过。人们发现了癌细胞的十大特征,发现了诸多癌症诱因,开发了诸多疗法,也尝试着发明了一些有效的癌症疫苗。最终效果怎么样呢?11月底,英国《每日邮报》发表了一篇文章,报道了近40年来多种癌症患者生存率的改善情况。有的癌症生存率较之以往增加了十年,有的只增加了短短3个星期。这说明,人类想要攻克癌症,依然任重而道远。
近年来,各种各样的抗癌药物被研制出来,但是癌细胞并不像人们想像的那样被“赶尽杀绝”。有时候,某种化疗药物已经杀死了99.99%的癌细胞,但是还是会有0.01%的癌细胞顺利逃脱药物“追击”,窜到身体其他地方继续生长壮大。这是因为癌细胞对抗癌药物的耐受性。有三种方式,可以让一部分癌细胞产生耐受性,免于死亡:遗传变异,表观遗传学改变和对某种蛋白进行选择性剪接……[详细]
近年来,各种各样的抗癌药物被研制出来,但是癌细胞并不像人们想像的那样被“赶尽杀绝”。有时候,某种化疗药物已经杀死了99.99%的癌细胞,但是还是会有0.01%的癌细胞顺利逃脱药物“追击”,窜到身体其他地方继续生长壮大。这是因为癌细胞对抗癌药物的耐受性。有三种方式,可以让一部分癌细胞产生耐受性,免于死亡:遗传变异,表观遗传学改变和对某种蛋白进行选择性剪接……[详细]

2011年3月4日,Douglas Hanahan和Robert A. Weinberg在《Cell》发表综述,题目为:Hallmarks of Cancer: The Next Generation。整个综述29页,简述了最近10年肿瘤学中的热点和进展(例如细胞自噬、肿瘤干细胞、肿瘤微环境等),并且将过去的6个特征扩增到10个特征,用一张图表示如下……[详细]


 随着癌症病例的增多以及大众对癌症认识的提高,现在有许多关于“致癌”的说法。药物刺激、身体创伤、衰老、遗传、抽烟、酗酒、不运动、吃烧烤、用塑料餐具、经常站在微波炉旁边、长时间用手机……这些似乎都可以致癌。但事实不见得如此。这里有些因素确实可以致癌,有些却是我们道听途说,没有理论依据的。英国《每日邮报》把我们常见的“致癌理论”综合到一起,再附上专家点评,让我们看看哪些是正确的,哪些只是谣传……[详细]
随着癌症病例的增多以及大众对癌症认识的提高,现在有许多关于“致癌”的说法。药物刺激、身体创伤、衰老、遗传、抽烟、酗酒、不运动、吃烧烤、用塑料餐具、经常站在微波炉旁边、长时间用手机……这些似乎都可以致癌。但事实不见得如此。这里有些因素确实可以致癌,有些却是我们道听途说,没有理论依据的。英国《每日邮报》把我们常见的“致癌理论”综合到一起,再附上专家点评,让我们看看哪些是正确的,哪些只是谣传……[详细]

这不是一组让人欣喜的数据。英国麦美伦癌症援助中心绘制出了在40多年的时间里,20种不同类型的癌症患者平均生存时间变化。他们发现,新的治疗方法显著改善了乳腺癌、结肠癌和非何杰金氏淋巴瘤患者的生存时间,但是对肺癌、恶性脑肿瘤和胰腺癌几乎没有丝毫改善。改善最明显的是结肠癌,患者生存时间从开始的7个月增长到10年。改善最不明显的是胰腺癌,患者生存时间从开始的9周上升到12周,只增加了短短3个星期。也难怪乔布斯会去世了……[详细]


 虽然过去40年,有些癌症生存率的改善微乎其微,但是这并不妨碍科学家研究、治疗癌症的脚步。2011年即将过去,在这一年里,科学家还是取得了一些巨大的进步。以下是Medscape评论员们挑选的2011年肿瘤学的10大突破事件,其中包括对神经母细胞瘤、肺癌、乳腺癌、胃肠道间质瘤、难治性淋巴瘤、转移性胰腺癌、白血病、恶性黑色素瘤的治疗,尤其是恶性黑色素瘤,科学家在这一块取得了前所未有的进展……[详细]
虽然过去40年,有些癌症生存率的改善微乎其微,但是这并不妨碍科学家研究、治疗癌症的脚步。2011年即将过去,在这一年里,科学家还是取得了一些巨大的进步。以下是Medscape评论员们挑选的2011年肿瘤学的10大突破事件,其中包括对神经母细胞瘤、肺癌、乳腺癌、胃肠道间质瘤、难治性淋巴瘤、转移性胰腺癌、白血病、恶性黑色素瘤的治疗,尤其是恶性黑色素瘤,科学家在这一块取得了前所未有的进展……[详细]


在对抗癌症的过程中,针对癌细胞开发抗癌药物是最直接有效的方法,但是从人体免疫系统入手,让机体自身的这道天然防线借助额外力量来攻击癌细胞也被证明是有效的,并且,它还没有传统化疗药物那样大的毒性。2010年4月,美国FDA批准了首个治疗性疫苗——Dendreon的Provenge,临床试验显示,对于某种特定类型的转移性前列腺癌男性患者,它可以延长大约4个月的生命。这里是FierceVaccines选取的8个治疗性癌症疫苗,它们还在临床研究阶段,但是已经颇受关注……[详细]







